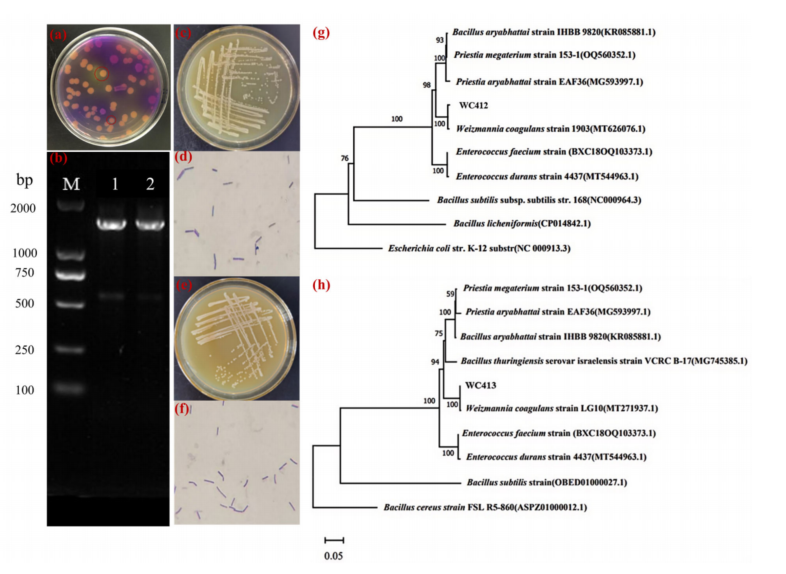

本网讯(通讯员 余翔)2025年8月,SCI期刊《Animals》(中科院2区)发表我院余翔博士的最新研究成果。论文题为“A Novel Weizmannia coagulans Strain WC412 with Superior Environmental Resilience Improves Growth Performance of Mice by Regulating the Intestinal Microbiota”。我院研究生肖雪和华中农业大学博士研究生黄昊为共同第一作者,余翔博士和荆楚理工学院张喜才博士为共同通讯作者,我院食用野生植物保育与利用湖北省重点实验室为第一通讯单位。

随着对可持续和无抗动物生产需求的增长,益生菌作为功能性饲料添加剂备受关注。本研究从泡菜水(一种尚未开发的益生菌筛选来源)中分离出新型凝结魏茨曼氏菌(Weizmannia coagulans)菌株WC412与WC413,并通过耐热性、耐酸性和耐胆盐测试,结合主成分分析(PCA)评估,筛选出环境抗逆性突出的WC412菌株。进一步的菌株WC412小鼠模型试验表明:中等剂量(1×10⁷ CFU·mL⁻¹)WC412可显著提升小鼠13%的体重增长(p<0.05),调节血清脂质谱,增强抗氧化酶活性及IgG/IL-2水平(p<0.05)。16S rDNA测序与KEGG分析揭示,饲喂中等剂量该菌株的小鼠肠道内特异性富集Fructilactobacillus和Limosilactobacillus等益生菌属,并促进短链脂肪酸合成相关代谢通路。研究结果证实凝结威茨曼氏菌WC412是一种能通过新型微生物群介导机制来改善动物生长性能和肠道健康的新型益生菌株。

研究工作得到了湖北省重点研发计划(2022BCE006)、湖北省自然科学基金(2023AFD025、2024AFB162)和荆楚理工学院研究生联合培养项目(No. YBYJS2407)的资助。(审核 李刚华)
